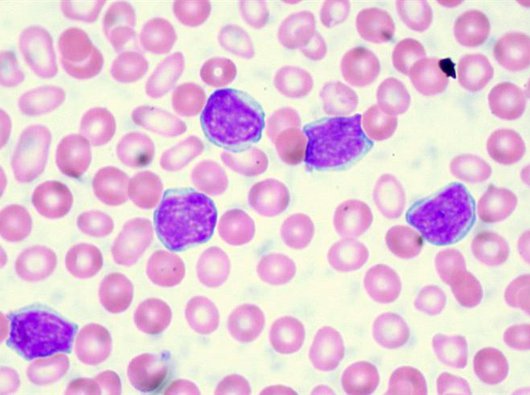

Our impact
We started with a girl named Susan, who passed away from leukaemia. In her memory, the Eastwood’s started sewing pocket squares to raise funds for research into this disease. This is where Blood Cancer UK was born.
Since then we’ve invested over £500million into research. In 1960 the survival rate for childhood leukaemia was just 10%, now that figure is 80% and rising. For people with all types of blood cancer, 60% now survive over 10 years
More people are surviving, we’re getting better at diagnosing blood cancer and people are receiving kinder treatments with fewer side effects but there’s still more to be done.
Because we’re determined to beat blood cancer within a generation.
1961
We begin to fund research in childhood leukaemia
The Eastwood family opened the first childhood leukaemia research unit at Great Ormond Street Hospital.

1968
We funded the first professorship in leukaemia research in Britain, powering forward key research
This cemented the importance of leukaemia research as an academic discipline in its own right.

1975
Scientists in Southampton developed an antibody that can stick to cancerous cells
This discovery laid the foundations for many treatments commonly used today.

1990
We developed a Minimal Residual Disease test for children to detect cancer cells left behind after initial treatment
This huge breakthrough transformed treatment outcomes for multiple blood cancers and is now used worldwide.

1993
We discovered a genetic change that happens in the womb which can cause childhood ALL
This discovery could be a ‘bullseye’ target for future treatments.

1999
We found the ‘Achilles heel’ of CML – a cancer stem cell which creates a stream of cancerous cells
Now, we want to create treatments that target this cell and destroy cancer at its root.
2004
We set up the national childhood leukaemia CellBank
This gave researchers access to clinical samples from children with leukaemia which has made it much easier for many researchers to carry out their work.

2005
We discovered a common mutation in a gene called JAK2 in people with myeloproliferative neoplasms
This changed the game for diagnosing and developing treatments for these diseases.

2011
We set up the Trials Acceleration Programme to ensure we deliver better treatments for blood cancer, faster
Over 1000 people have benefited from 20 trials which help change clinical practice and advance treatment.

2012
We developed a test for people with myeloma which helps doctors understand how their disease might develop
These are now used across Europe.

2015
Our clinical trial called RAPID showed the benefits of giving people with Hodgkin lymphoma body scans before and after treatment
This trial changed clinical practice worldwide and means fewer people now need radiotherapy.

2018
The DESTINY trial showed that it may be possible to pause treatment for some people with CML
This could give them a break from the side effects.

2019
The CLARITY trial showed that ibrutinib and venetoclax were a highly effective treatment combination for people with CLL
The combination of drugs was able to destroy cancer cells with fewer side effects that traditional treatment.




